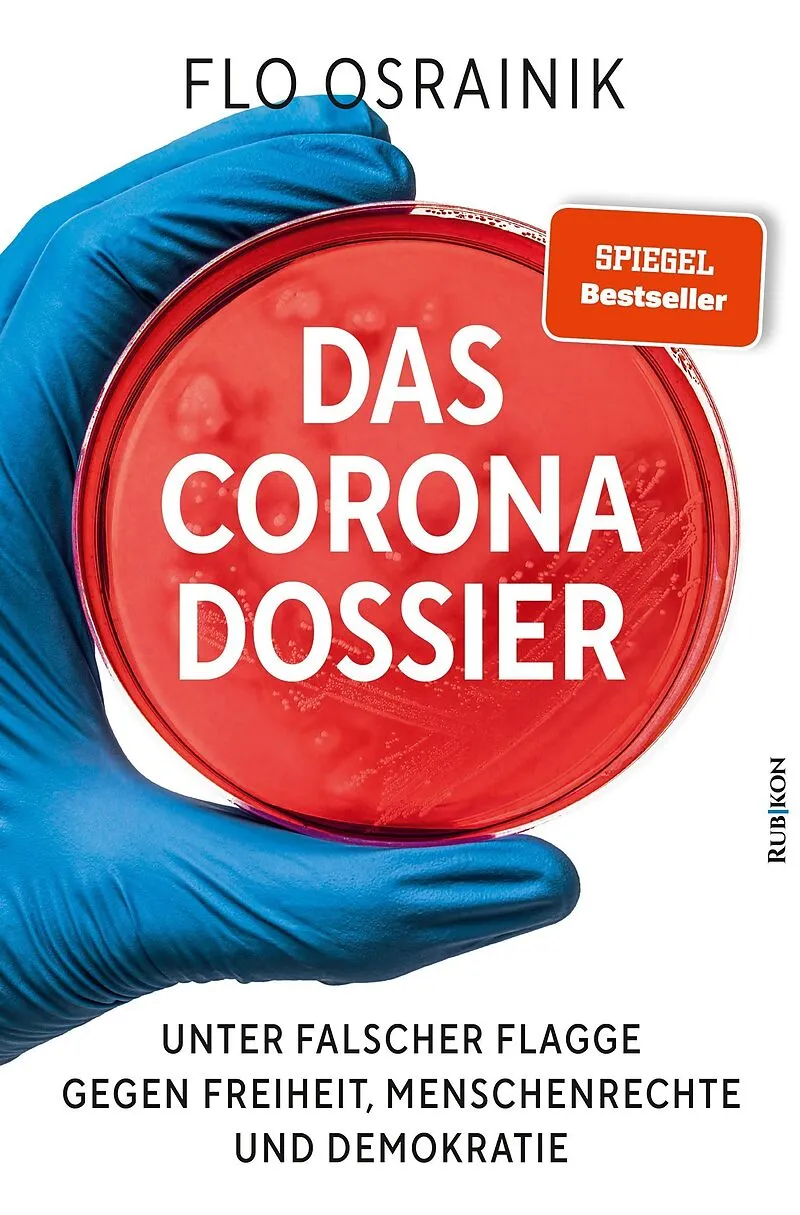

Willkommen. Schön, sind Sie da!
0

Das Corona-Dossier
Von:
Beschreibung
Corona hier, Corona da, Corona überall. Seit nunmehr einem Jahr kennt die Politik kein anderes Thema mehr und verbreiten die Massenmedien gezielt Angst und Schrecken, um die Menschen im Dauerstress zu halten und die Entscheidungen der Mächtigen als alternativl...Format auswählen
- Kartonierter EinbandCHF 29.20
Kartonierter Einband
CHF29.20
TIEFPREIS
CHF29.20
Auslieferung erfolgt in der Regel innert 5 bis 7 Werktagen.
Kostenlose Lieferung